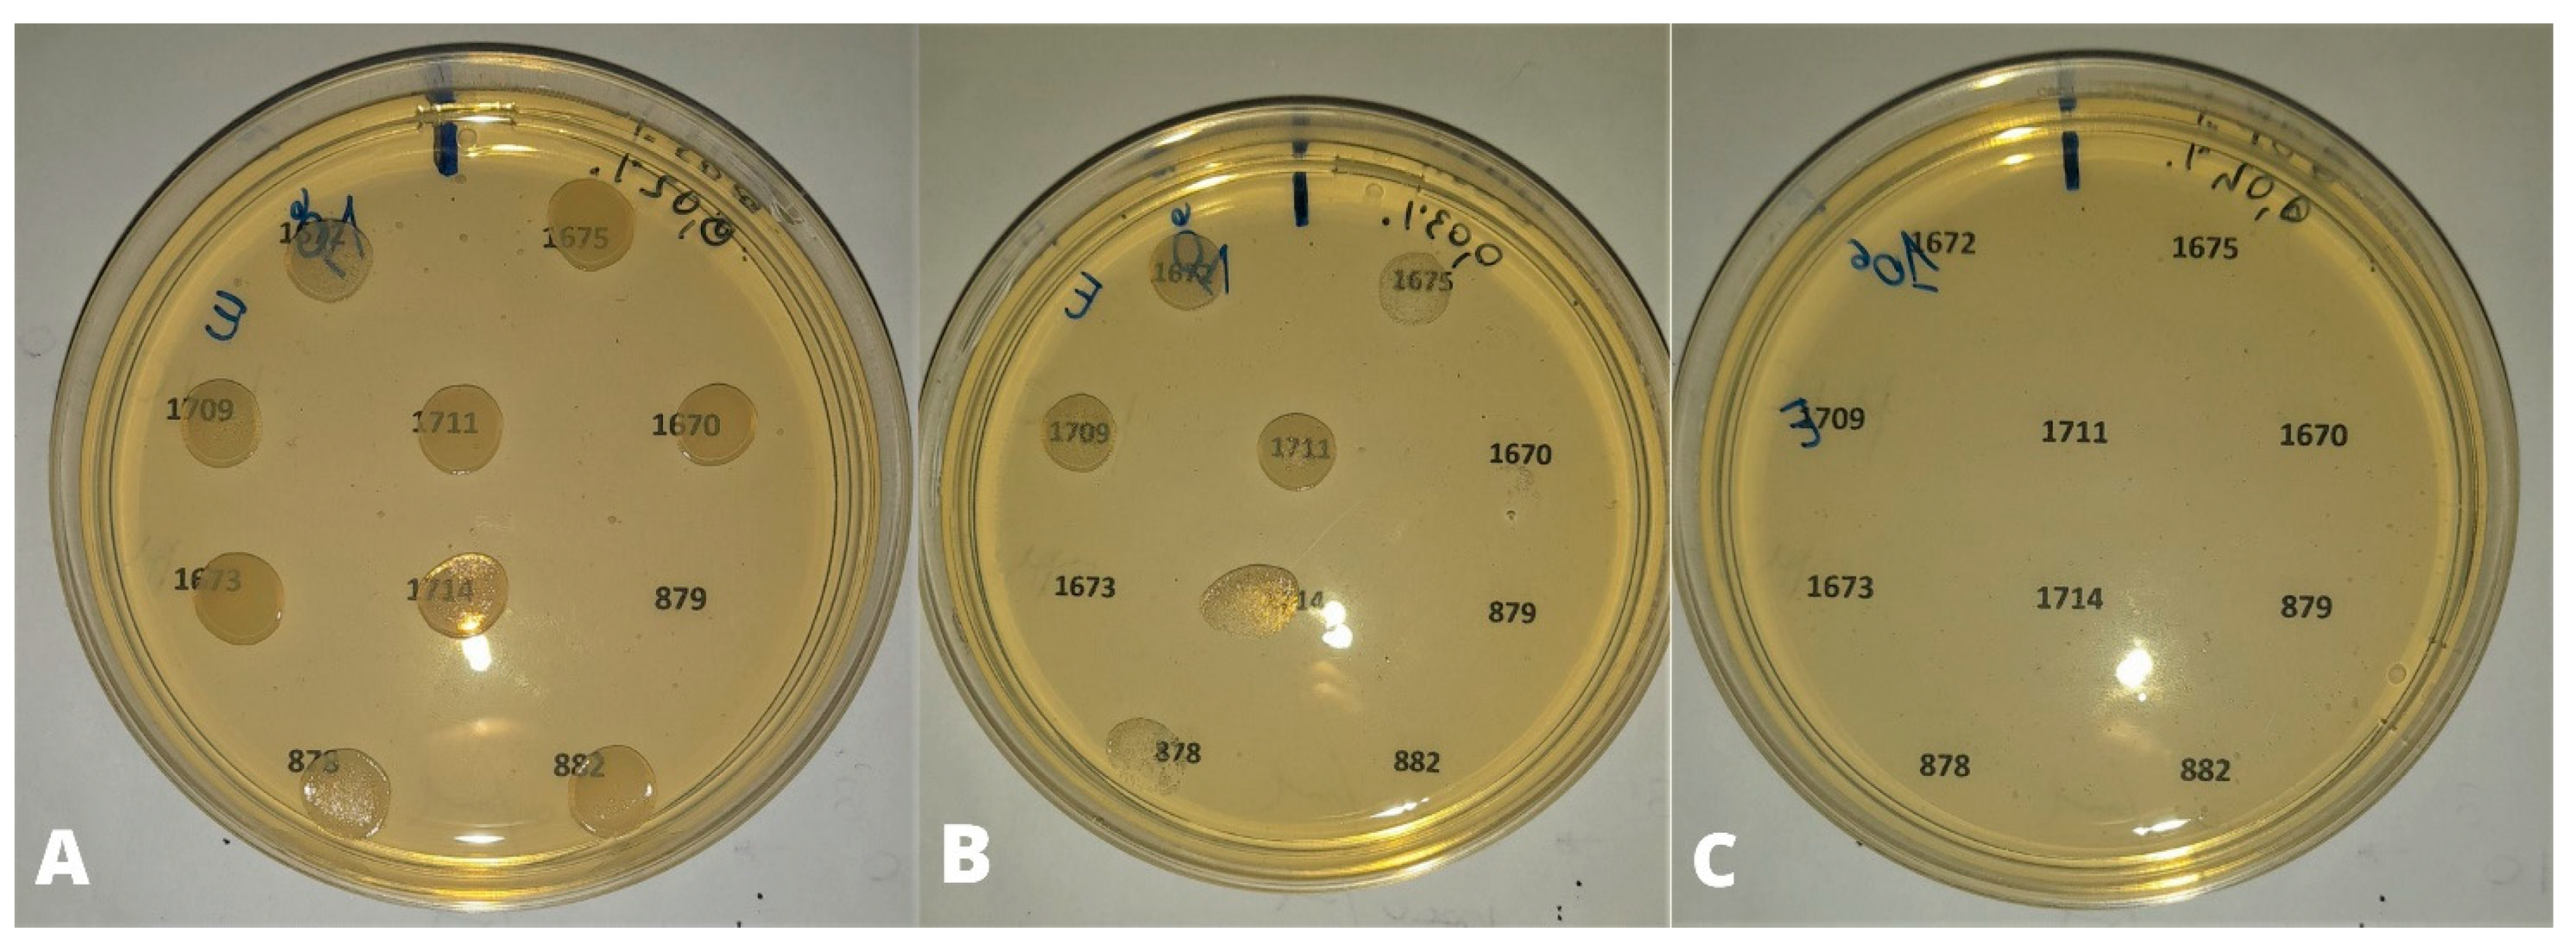
Animals 13 02639 g003 550

Antimicrobial Efficacy of Cinnamon Essential Oil against Avian Pathogenic Escherichia coli from Poultry
Abstract
:Simple Summary
Abstract
1. Introduction
2. Material and Methods
2.1. Bacterial Strains Used for the Experiment
2.2. Preparation of Bacterial Suspensions
2.3. Cinnamon Essential Oil and Preparation of Medium
2.4. Preliminary Test
2.5. Preparation of the Efficacy Tests
2.6. Statistical Analysis
3. Results
3.1. Preliminary Tests
3.2. Efficacy Tests
4. Discussion
5. Conclusions
Author Contributions
Funding
Institutional Review Board Statement
Data Availability Statement
Conflicts of Interest
References
- Sarowska, J.; Futoma-Koloch, B.; Jama-Kmiecik, A.; Frej-Madrzak, M.; Ksiazczyk, M.; Bugla-Ploskonska, G.; Choroszy-Krol, I. Virulence factors, prevalence and potential transmission of extraintestinal pathogenic Escherichia coli isolated from different sources: Recent reports. Gut Pathog. 2019, 11, 10. [Google Scholar] [CrossRef] [PubMed]
- Denamur, E.; Clermont, O.; Bonacorsi, S.; Gordon, D. The population genetics of pathogenic Escherichia coli. Nat. Rev. Microbiol. 2021, 19, 37–54. [Google Scholar] [CrossRef] [PubMed]
- La Ragione, R.; Woodward, M. Virulence factors of Escherichia coli serotypes associated with avian colisepticaemia. Res. Vet. Sci. 2002, 73, 27–35. [Google Scholar] [CrossRef]
- Schouler, C.; Schaeffer, B.; Bree, A.; Mora, A.; Dahbi, G.; Biet, F.; Oswald, E.; Mainil, J.; Blanco, J.; Moulin-Schouleur, M. Diagnostic Strategy for Identifying Avian Pathogenic Escherichia coli Based on Four Patterns of Virulence Genes. J. Clin. Microbiol. 2012, 50, 1673–1678. [Google Scholar] [CrossRef]
- Kaper, J.B.; Nataro, J.P.; Mobley, H.L. Pathogenic Escherichia coli. Nat. Rev. Microbiol. 2004, 2, 123–140. [Google Scholar] [CrossRef]
- Nolan, L.K.; Vaillancourt, J.P.; Barbieri, N.L.; Logue, C.M. Diseases of Poultry, 14th ed.; John Wiley & Sons: Hoboken, NJ, USA, 2020; pp. 770–830. [Google Scholar]
- Dziva, F.; Stevens, M.P. Colibacillosis in poultry: Unravelling the molecular basis of virulence of avian pathogenic Escherichia coli in their natural hosts. Avian Pathol. 2008, 37, 355–366. [Google Scholar] [CrossRef]
- Palaniyandi, S.; Mitra, A.; Herren, C.D.; Zhu, X.; Mukhopadhyay, S. LuxS contributes to virulence in avian pathogenic Escherichia coli O78:K80:H9. Vet. Microbiol. 2013, 166, 567–575. [Google Scholar] [CrossRef] [PubMed]
- Ma, J.; Bao, Y.; Sun, M.; Dong, W.; Pan, Z.; Zhang, W.; Lu, C.; Yao, H. Two functional type VI secretion systems in avian pathogenic Escherichia coli are involved in different pathogenic pathways. Infect. Immun. 2014, 82, 3867–3879. [Google Scholar] [CrossRef]
- Wang, S.; Xu, X.; Liu, X.; Wang, D.; Liang, H.; Wu, X.; Tian, M.; Ding, C.; Wang, G.; Yu, S. Escherichia coli type III secretion system 2 regulator EtrA promotes virulence of avian pathogenic Escherichia coli. Microbiology 2017, 163, 1515–1524. [Google Scholar] [CrossRef]
- Li, Q.; Yin, L.; Xue, M.; Wang, Z.; Song, X.; Shao, Y.; Liu, H.; Tu, J.; Qi, K. The transcriptional regulator PhoP mediates the tolC molecular mechanism on APEC biofilm formation and pathogenicity. Avian Pathol. 2020, 49, 211–220. [Google Scholar] [CrossRef]
- Osman, K.M.; Kappell, A.D.; Elhadidy, M.; El-Mougy, F.; El-Ghany, W.A.; Orabi, A.; Mubarak, A.S.; Dawoud, T.M.; Hemeg, H.A.; Moussa, I.M.; et al. Poultry hatcheries as potential reservoirs for antimicrobial-resistant Escherichia coli: A risk to public health and food safety. Sci. Rep. 2018, 8, 5859. [Google Scholar] [CrossRef]
- Circella, E.; Pennelli, D.; Tagliabue, S.; Camarda, A. Virulence-associated genes in avian pathogenic Escherichia coli from laying hens in Apulia, southern Italy. Br. Poult. Sci. 2012, 53, 465–470. [Google Scholar] [CrossRef] [PubMed]
- Mellata, M. Human and avian extraintestinal pathogenic Escherichia coli infections, zoonotic risks, and antibiotic resistance trends. Foodborne Pathog. Dis. 2013, 10, 916–932. [Google Scholar] [CrossRef] [PubMed]
- Zanella, A.; Alborali, G.L.; Bardotti, M.; Candotti, P.; Guadagnini, P.F.; Anna Martino, P.; Stonfer, M. Severe Escherichia coli O111 septicaemia and polyserositis in hens at the start of lay. Avian Pathol. 2000, 29, 311–317. [Google Scholar] [CrossRef] [PubMed]
- Khafagy, A.; Eid, S.; Mohammed, R. Phenotypic Characterization of Escherichia coli Isolated from Broiler Chicken. SCVMJ 2019, 24, 143–150. [Google Scholar] [CrossRef]
- Giovanardi, D.; Campagnari, E.; Ruffoni Sperati, L.; Pesente, P.; Ortali, G.; Furlattini, V. Avian pathogenic Escherichia coli transmission from broiler breeders to their progeny in an integrated poultry production chain. Avian Pathol. 2005, 34, 313–318. [Google Scholar] [CrossRef]
- Barnes, H.J.; Gross, W.B. Diseases of Poultry, 10th ed.; Wiley & Sons: Ames, IA, USA, 1997; pp. 131–141. [Google Scholar]
- Gomis, S.; Babiuk, L.; Allan, B.; Willson, P.; Waters, E.; Hecker, R.; Potter, A. Protection of chickens against a lethal challenge of Escherichia coli by a vaccine containing cpg oligodeoxynucleotides (cpg-odn) as an adjuvant. Avian Dis. 2007, 51, 78–83. [Google Scholar] [CrossRef]
- Gregersen, R.H.; Christensen, H.; Ewers, C.; Bisgaard, M. Impact of Escherichia coli vaccine on parent stock mortality, first week mortality of broilers and population diversity of E. coli in vaccinated flocks. Avian Path. 2010, 39, 287–295. [Google Scholar] [CrossRef]
- Hera, A.; Bures, J. Veterinary autogenous vaccines. Dev. Biol. 2004, 117, 19–25. [Google Scholar]
- Landman, W.J.; Van Eck, J.H. The efficacy of inactivated Escherichia coli autogenous vaccines against the E. coli peritonitis syndrome in layers. Avian Path. 2017, 46, 658–665. [Google Scholar] [CrossRef]
- European Medicine Agency. Summary of the European Public Assessment Report (EPAR) for Poulvac E. coli. Available online: https://www.ema.europa.eu/en/medicines/veterinary/EPAR/poulvac-e-coli (accessed on 4 May 2020).
- Galal, H.M.; Tawfek, A.M.; Abdrabou, M.I.; Hessain, A.M.; Alhaaji, J.H.; Kabli, S.A.; Elbehiry, A.; Alwarhi, W.K.; Moussa, I.M. Recent approaches for control of E. coli and respiratory complex in Middle East. Saudi J. Biol. Sci. 2018, 25, 1302–1307. [Google Scholar] [CrossRef] [PubMed]
- Guabiraba, R.; Schouler, C. Avian colibacillosis: Still many black holes. FEMS Microbiol. Lett. 2015, 362, fnv118. [Google Scholar] [CrossRef] [PubMed]
- Koutsianos, D.; Gantelet, H.; Franzo, G.; Lecoupeur, M.; Thibault, E.; Cecchinato, M.; Koutoulis, K.C. An Assessment of the Level of Protection Against Colibacillosis Conferred by Several Autogenous and/or Commercial Vaccination Programs in Conventional Pullets upon Experimental Challenge. Vet. Sci. 2020, 7, 80. [Google Scholar] [CrossRef]
- Casalino, G.; Bozzo, G.; Dinardo, F.R.; D’Amico, F.; Dimuccio, M.M.; Camarda, A.; Ceci, E.; Romito, D.; Circella, E. Prevalence and antimicrobial resistence of Campylobacter jejuni and Campylobacter coli from laying hens housed in different rearing systems. Animals 2022, 12, 2978. [Google Scholar] [CrossRef] [PubMed]
- World Organisation for Animal Health. Strategy on Antimicrobial Resistance and the Prudent Use of Antimicrobials. Available online: https://www.oie.int/fileadmin/Home/eng/Media_Center/docs/pdf/PortailAMR/EN_OIE-AMRstrategy.pdf (accessed on 18 November 2016).
- European Union Regulation (EU) 2018/848: Of the European Parliament and of the Council of 30 May 2018 on Organic Production and Labelling of Organic Products and Repealing Council Regulation. Available online: https://eur-lex.europa.eu/legal-content/EN/TXT/?uri=CELEX%3A32018R0848 (accessed on 14 June 2018).
- Gadde, U.; Kim, W.H.; Oh, S.T.; Lillehoj, H.S. Alternatives to Antibiotics for Maximizing Growth Performance and Feed Efficiency in Poultry: A Review. Anim. Health Res. Rev. 2017, 18, 26–45. [Google Scholar] [CrossRef] [PubMed]
- Haque, M.H.; Sarker, S.; Islam, M.S.; Islam, M.A.; Karim, M.R.; Kayesh, M.E.; Shiddiky, M.J.; Anwer, M.S. Sustainable Antibiotic-Free Broiler Meat Production: Current Trends, Challenges, and Possibilities in a Developing Country Perspective. Biology 2020, 9, 411. [Google Scholar] [CrossRef]
- Farooq, M.; Smoglica, C.; Ruffini, F.; Soldati, L.; Marsilio, F.; Di Francesco, C.E. Antibiotic Resistance Genes Occurrence in Conventional and Antibiotic-Free Poultry Farming, Italy. Animals 2022, 12, 2310. [Google Scholar] [CrossRef]
- Adaszyńska-Skwirzyńska, M.; Szczerbińska, D. Use of Essential Oils in Broiler Chicken Production—A Review. Ann. Anim. Sci. 2017, 17, 317–335. [Google Scholar] [CrossRef]
- Bae, K.H.; Ji, J.M.; Park, K.L. The antibacterial component from Cinnamomic Cortex against a cariogenic bacterium Streptococcus mutans OMZ 176. Arch. Pharm. Res. 1992, 15, 239–241. [Google Scholar] [CrossRef]
- Dayananda, K.R.; Senanayake, U.M.; Wijesekera. Cinnamon and Cassia. The Genus Cinnamomum, 1st ed.; CRC Press: Boca Raton, FL, USA, 2003; pp. 130–156. [Google Scholar]
- Vasconcelos, N.G.; Croda, J.; Simionatto, S. Antibacterial mechanisms of cinnamon and its constituents: A review. Microb. Pathog. 2018, 120, 198–203. [Google Scholar] [CrossRef]
- Thomas, J.; Kuruvilla, K.M. Cinnamon. Handb. Herbs Spices 2012, 1, 182–196. [Google Scholar]
- Nabavi, S.F.; Di Lorenzo, A.; Izadi, M.; Sobarzo-Sánchez, E.; Daglia, M.; Nabavi, S.M. Antibacterial Effects of Cinnamon: From Farm to Food, Cosmetic and Pharmaceutical Industries. Nutrients 2015, 7, 7729–7748. [Google Scholar] [CrossRef]
- Clinical and Laboratory Standards Institute (CLSI). Available online: https://www.nih.org.pk/wp-content/uploads/2021/02/CLSI-2020.pdf (accessed on 1 January 2020).
- Circella, E.; Casalino, G.; D’Amico, F.; Pugliese, N.; Dimuccio, M.M.; Camarda, A.; Bozzo, G. In vitro antimicrobial effectiveness tests using Garlic (Allium sativum) against Salmonella enterica subspecies enterica serovar Enteritidis. Antibiotics 2022, 11, 1481. [Google Scholar] [CrossRef]
- Abd El-Hack, M.E.; Alagawany, M.; Abdel-Moneim, A.M.; Mohammed, N.G.; Khafaga, A.F.; Bin-Jumah, M.; Othman, S.I.; Allam, A.A.; Elnesr, S.S. Cinnamon (Cinnamomum zeylanicum) oil as a potential alternative to antibiotics in poultry. Antibiotics 2020, 9, 210. [Google Scholar] [CrossRef] [PubMed]
- Bassolé, I.H.; Juliani, H.R. Essential oils in combination and their antimicrobial properties. Molecules 2012, 17, 3989–4006. [Google Scholar] [CrossRef] [PubMed]
- Burt, S. Essential oils: Their antibacterial properties and potential applications in foods—A review. Int. J. Food Microbiol. 2004, 94, 223–253. [Google Scholar] [CrossRef] [PubMed]
- Juven, B.J.; Kanner, J.; Schved, F.; Weisslowicz, H. Factors that interact with the antibacterial action of thyme essential oil and its active constituents. J. Appl. Bacteriol. 1994, 76, 626–631. [Google Scholar] [CrossRef]
- Sikkema, J.; de Bont, J.A.; Poolman, B. Mechanism of membrane toxicity of hydrocarbons. Micobiol. Rev. 1995, 59, 201–222. [Google Scholar] [CrossRef] [PubMed]
- Hsouna, A.B.; Trigui, M.; Mansour, R.B.; Jarraya, R.M.; Damak, M.; Jaoua, S. Chemical composition, cytotoxicity effect and antimicrobial activity of Ceratonia siliqua essential oil with preservative effects against Listeria inoculated in minced beef meat. Int. J. Food Microbiol. 2011, 148, 66–72. [Google Scholar] [CrossRef]
- Zhang, Y.; Liu, X.; Wang, Y.; Jiang, P.; Quek, S. Antibacterial activity and mechanism of cinnamon essential oil against Escherichia coli and Staphylococcus aureus. Food Control 2016, 59, 282–289. [Google Scholar] [CrossRef]
- Pereira, W.A.; Pereira, C.D.; Assunção, R.G.; da Silva, I.S.; Rego, F.S.; Alves, L.S.; Santos, J.S.; Nogueira, F.J.; Zagmignan, A.; Thomsen, T.T.; et al. New insights into the antimicrobial action of cinnamaldehyde towards Escherichia coli and its effects on intestinal colonization of mice. Biomolecules 2021, 11, 302. [Google Scholar] [CrossRef] [PubMed]
- He, T.F.; Wang, L.H.; Niu, D.B.; Wen, Q.H.; Zeng, X.A. Cinnamaldehyde inhibit Escherichia coli associated with membrane disruption and oxidative damage. Arch. Microbiol. 2019, 201, 451–458. [Google Scholar] [CrossRef] [PubMed]
- Shen, S.; Zhang, T.; Yuan, Y.; Lin, S.; Xu, J.; Ye, H. Effects of cinnamaldehyde on Escherichia coli and Staphylococcus aureus membrane. Food Control 2015, 47, 196–202. [Google Scholar] [CrossRef]
- Da Silva, G.J.; Mendonça, N. Association between antimicrobial resistance and virulence in Escherichia coli. Virulence 2012, 3, 18–28. [Google Scholar] [CrossRef]
- He, T.F.; Zhang, Z.H.; Zeng, X.A.; Wang, L.H.; Brennan, C.S. Determination of membrane disruption and genomic DNA binding of cinnamaldehyde to Escherichia coli by use of microbiological and spectroscopic techniques. J. Photochem. Photobiol. B Biol. 2018, 178, 623–630. [Google Scholar] [CrossRef] [PubMed]
- Usha, M.; Ragini, S.; Naqvi, S.M. Antibacterial activity of acetone and ethanol extracts of cinnamon (Cinnamomum zeylanicum) and Ajowan (Trachyspermum ammi) on four food spoilage bacteria. I. Res. J. Biol. Sci. 2012, 1, 7–11. [Google Scholar]
- Prabuseenivasan, S.; Javakumar, M.; Ignacimuthu, S. In vitro antibacterial activuty of some plant essential oils. BMC Complement. Altern. Med. 2006, 6, 39. [Google Scholar] [CrossRef] [PubMed]
- Raeisi, M.; Tajik, H.; Yarahmadi, A.; Sanginabadi, S. Antimicrobial Effect of Cinnamon Essential Oil Against Escherichia Coli and Staphylococcus aureus. Health Scope 2015, 4, 1–5. [Google Scholar] [CrossRef]
- Lu, C.; Liu, H.; Shangguan, W.; Chen, S.; Zhong, Q. Antibiofilm activities of the cinnamon extract against Vibrio parahaemolyticus and Escherichia coli. Arch. Microbiol. 2021, 203, 125–135. [Google Scholar] [CrossRef]
- Wardatun, S.; Rustiani, E.; Alfiani, N.; Rissani, D. Study effect type of extraction method and type of solvent to cinnamaldehyde and trans-cinnamic acid dry extract cinnamon (Cinnamomum burmanii [Nees & T, Nees] Blume). J. Young Pharm. 2017, 9, 49–51. [Google Scholar]
- Masghati, S.; Ghoreishi, S.M. Supercritical CO2 extraction of cinnamaldehyde and eugenol from cinnamon bark: Optimization of operating conditions via response surface methodology. J. Supercrit. Fluids 2018, 140, 62–71. [Google Scholar] [CrossRef]
- Baseri, H.; Haghighi-Asl, A.; Lotfollahi, M.N. Effects of Operating Parameters on the Cinnamaldehyde Content of Extracted Essential Oil Using Various Methods. Chem. Eng. Technol. 2010, 33, 267–274. [Google Scholar] [CrossRef]
- Friedman, M.; Kozukue, N.; Harden, L.A. Cinnamaldehyde content in foods determined by gas chromatography-mass spectrometry. J. Agric. Food Chem. 2000, 48, 5702–5709. [Google Scholar] [CrossRef] [PubMed]
- Muhoza, B.; Qi, B.; Harindintwali, J.D.; Koko, M.Y.; Zhang, S.; Li, Y. Encapsulation of cinnamaldehyde: An insight on delivery systems and food applications. Crit. Rev. Food Sci. Nutr. 2023, 63, 2521–2543. [Google Scholar] [CrossRef] [PubMed]
- Yu, C.; Li, Y.L.; Liang, M.; Dai, S.Y.; Ma, L.; Li, W.G.; Lai, F.; Liu, X.M. Characteristics and hazards of the cinnamaldehyde oxidation process. RSC Adv. 2020, 10, 19124–19133. [Google Scholar] [CrossRef]
- Sedaghat, D.; Dewettinck, K.; Devlieghere, F.; Van der Meeren, P. Influence of non-ionic emulsifier type on the stability of cinnamaldehyde nanoemulsions: A comparison of polysorbate 80 and hydrophobically modified inulin. Food Chem. 2018, 258, 237–244. [Google Scholar] [CrossRef]
- Kazemi, M.; Mokhtariniya, S. Essential oil composition of bark of Cinnamomum zeylanicum. J. Essent. Oil-Bear. Plants 2016, 19, 786–789. [Google Scholar] [CrossRef]
- Boughendjioua, H.; Djeddi, S. Study of The Organoleptic and Physicochemical Properties of Cinnamon Essential Oil (Cinnamomum zeylanicum). Am. J. Life Sci. Res. 2018, 6, 123–130. [Google Scholar]
- Asdrubali, G.; Bolognesi, P.G.; Cabassi, C.S.; Camarda, A.; Catelli, E.; Circella, E.; Cringoli, G.; Delogu, M.; Di Modugno, G.; Dipineto, L.; et al. Manuale di Patologia Aviare, 1st ed.; Le Point Vétérinaire Italie srl: Milan, Italy, 2009; pp. 77–84. [Google Scholar]
- Paniagua-Contreras, G.L.; Monroy-Pérez, E.; Rodríguez-Moctezuma, J.R.; Domínguez-Trejo, P.; Vaca-Paniagua, F.; Vaca, S. Virulence factors, antibiotic resistance phenotypes and O-serogroups of Escherichia coli strains isolated from community acquired urinary tract infection patients in Mexico. J. Microbiol. Immunol. Infect. 2017, 50, 478–485. [Google Scholar] [CrossRef]
- Nakazato, G.; Campos, T.A.; Stehling, E.G.; Brocchi, M.; Silveira, W.D. Virulence factors of avian pathogenic Escherichia coli (APEC). Pesqui. Vet. Bras. 2009, 29, 479–486. [Google Scholar] [CrossRef]
- Mellata, M.; Dho-Moulin, M.; Dozois, C.M.; Curtiss, R.; Brown, P.K.; Arnè, P.; Bréè, A.; Desautels, C.; Fairbrother, J.M. Role of virulence factors in resistance of avian pathogenic Escherichia coli to serum and in pathogenicity. Infect. Immun. 2003, 71, 536–540. [Google Scholar] [CrossRef] [PubMed]
- Becerril, R.; Nerín, C.; Gómez-Lus, R. Evaluation of bacterial resistance to essential oils and antibiotics after exposure to oregano and cinnamon essential oils. Foodborne Pathog. Dis. 2012, 9, 699–705. [Google Scholar] [CrossRef] [PubMed]
- Mohamed, M.A.; Shehata, M.A.; Rafeek, E. Virulence genes content and antimicrobial resistance in Escherichia colifrom broiler chickens. Vet. Med. Int. 2014, 2014, 195189. [Google Scholar] [CrossRef]
- El Atki, Y.; Aouam, I.; El Kamari, F.; Taroq, A.; Nayme, K.; Timinouni, M.; Lyoussi, B.; Abdellaoui, A. Antibacterial activity of cinnamon essential oils and their synergistic potential with antibiotics. J. Adv. Pharm. Technol. Res. 2019, 10, 63–67. [Google Scholar] [CrossRef]
- Yap, P.S.; Lim, S.H.; Hu, C.P.; Yiap, B.C. Combination of essential oils and antibiotics reduce antibiotic resistance in plasmid-conferred multidrug resistant bacteria. Phytomedicine 2013, 20, 710–713. [Google Scholar] [CrossRef]
- Utchariyakiat, I.; Surassmo, S.; Jaturanpinyo, M.; Khuntayaporn, P.; Chomnawang, M.T. Efficacy of cinnamon bark oil and cinnamaldehyde on anti-multidrug resistant Pseudomonas aeruginosa and the synergistic effects in combination with other antimicrobial agents. BMC Complement. Altern. Med. 2016, 16, 158. [Google Scholar] [CrossRef]
- El-Hosseiny, L.; El-Shenawy, M.; Haroun, M.; Abdullah, F. Comparative evaluation of the inhibitory effect of some essential oils with antibiotics against Pseudomonas aeruginosa. Int. J. Antibiot. 2014, 2014, 586252. [Google Scholar] [CrossRef]
- Lorenzi, V.; Muselli, A.; Bernardini, A.F.; Berti, L.; Pagès, J.M.; Amaral, L.; Bolla, J.M. Geraniol restores antibiotic activities against multidrug-resistant isolates from gram-negative species. Antimicrob. Agents Chemother. 2009, 53, 2209–2211. [Google Scholar] [CrossRef]
- D’Arrigo, M.; Ginestra, G.; Mandalari, G.; Furneri, P.M.; Bisignano, G. Synergism and postantibiotic effect of tobramycin and Melaleuca alternifolia (tea tree) oil against Staphylococcus aureus and Escherichia coli. Phytomedicine 2010, 17, 317–322. [Google Scholar] [CrossRef] [PubMed]
- Kwiatkowski, P.; Mnichowska-Polanowska, M.; Pruss, A.; Masiuk, H.; Dzięcioł, M.; Giedrys-Kalemba, S.; Sienkiewicz, M. The effect of fennel essential oil in combination with antibiotics on Staphylococcus aureus strains isolated from carriers. Burns 2017, 43, 1544–1551. [Google Scholar] [CrossRef]
- Kohlert, C.; Schindler, G.; März, R.W.; Abel, G.; Brinkhaus, B.; Derendorf, H.; Gräfe, E.U.; Veit, M. Systemic availability and pharmacokinetics of thymol in humans. J. Clin. Pharmacol. 2002, 42, 731–737. [Google Scholar] [CrossRef] [PubMed]
- Peters, M.M.; Caldwell, J. Studies on trans-cinnamaldehyde. I. The influence of dose size and sex on its disposition in the rat and mouse. Food Chem. Toxicol. 1994, 32, 869–876. [Google Scholar] [CrossRef] [PubMed]
- Diaz-Sanchez, S.; D’Souza, D.; Biswas, D.; Hanning, I. Botanical alternatives to antibiotics for use in organic poultry production. Poult. Sci. 2015, 94, 1419–1430. [Google Scholar] [CrossRef] [PubMed]
- Delaquis, P. Antimicrobial activity of individual and mixed fractions of dill, cilantro, coriander and eucalyptus essential oils. Int. J. Food Microbiol. 2002, 74, 101–109. [Google Scholar] [CrossRef]
- Santiesteban-López, A.; Palou, E.; López-Malo, A. Susceptibility of food-borne bacteria to binary combinations of antimicrobials at selected awand pH. J. Appl. Microbiol. 2007, 102, 485–497. [Google Scholar] [CrossRef]
- Gutierrez, J.; Barry-Ryan, C.; Bourke, P. The antimicrobial efficacy of plant essential oil combinations and interactions with food ingredients. Int. J. Food Microbiol. 2008, 124, 91–97. [Google Scholar] [CrossRef]
- Ali, S.; Khan, A.; Ahmed, I.; Musaddiq, M.; Ahmed, K.; Polasa, H.; Rao, L.V.; Habibullah, C.M.; Sechi, L.A.; Ahmed, N. Antimicrobial activities of eugenol and cinnamaldehyde against the human gastric pathogen Helicobacter pylori. Ann. Clin. Microbiol. Antimicrob. 2005, 4, 20. [Google Scholar] [CrossRef]
- Ali, A.; Ponnampalam, E.N.; Pushpakumara, G.; Cottrell, J.J.; Suleria, H.A.; Dunshea, F.R. Cinnamon: A Natural Feed Additive for Poultry Health and Production—A Review. Animals 2021, 11, 2026. [Google Scholar] [CrossRef]
- Jang, I.S.; Ko, Y.H.; Kang, S.Y.; Lee, C.Y. Effect of a commercial essential oil on growth performance, digestive enzyme activity and intestinal microflora population in broiler chickens. Anim. Feed Sci. Technol. 2007, 134, 304–315. [Google Scholar] [CrossRef]
- Chowdhury, S.; Mandal, G.P.; Patra, A.K.; Kumar, P.; Samanta, I.; Pradhan, S.; Samanta, A.K. Different essential oils in diets of broiler chickens: 2. Gut microbes and morphology, immune response, and some blood profile and antioxidant enzymes. Anim. Feed Sci. Technol. 2018, 236, 39–47. [Google Scholar] [CrossRef]
- Kettunen, H.; Ouwehand, A.; Schulze, H.; Rautonen, N. Dietary essential oil supplementation enhanced intestinal immunocompetence in young broiler chick. Reprod. Nutr. Dev. 2006, 46, S101. [Google Scholar]

| Species | N° Strains | Cinnamon Essential Oil (µL/mL) | Strains Inhibited (%) | p-Value |
|---|---|---|---|---|
| Laying hens | 91 | 0.1 | 0 (0) | <0.001 |
| 0.2 | 0 (0) | |||
| 0.3 | 1 (1.09) | |||
| 0.4 | 59 (64.83) | |||
| 0.5 | 90 (98.9) | |||
| 0.6 | 91 (100) | |||
| 0.7 | 91 (100) | |||
| 0.8 | 91 (100) | |||
| Turkeys | 16 | 0.1 | 0 (0) | <0.001 |
| 0.2 | 0 (0) | |||
| 0.3 | 2 (12.5) | |||
| 0.4 | 3 (18.75) | |||
| 0.5 | 14 (87.5) | |||
| 0.6 | 16 (100) | |||
| 0.7 | 16 (100) | |||
| 0.8 | 16 (100) | |||
| Broilers | 10 | 0.1 | 0 (0) | <0.001 |
| 0.2 | 0 (0) | |||
| 0.3 | 1 (10) | |||
| 0.4 | 4 (40) | |||
| 0.5 | 10 (100) | |||
| 0.6 | 10 (100) | |||
| 0.7 | 10 (100) | |||
| 0.8 | 10 (100) | |||
| TOTAL | 117 | 0.1 | 0 (0) | <0.001 |
| 0.2 | 0 (0) | |||
| 0.3 | 4 (3.41) | |||
| 0.4 | 66 (56.41) | |||
| 0.5 | 114 (97.43) | |||
| 0.6 | 117 (100) | |||
| 0.7 | 117 (100) | |||
| 0.8 | 117 (100) |
| Serogroups | N° Strains | Cinnamon Essential Oil (µL/mL) | Strains Inhibited (%) | p-Value |
|---|---|---|---|---|
| O78 | 54 | 0.1 | 0 (0) | <0.001 |
| 0.2 | 0 (0) | |||
| 0.3 | 3 (5.56) | |||
| 0.4 | 27 (50) | |||
| 0.5 | 53 (98.15) | |||
| 0.6 | 54 (100) | |||
| 0.7 | 54 (100) | |||
| 0.8 | 54 (100) | |||
| O2 | 37 | 0.1 | 0 (0) | <0.001 |
| 0.2 | 0 (0) | |||
| 0.3 | 1 (2.7) | |||
| 0.4 | 26 (70.27) | |||
| 0.5 | 35 (94.59) | |||
| 0.6 | 37 (100) | |||
| 0.7 | 37 (100) | |||
| 0.8 | 37 (100) | |||
| O139 | 19 | 0.1 | 0 (0) | <0.001 |
| 0.2 | 0 (0) | |||
| 0.3 | 0 (0) | |||
| 0.4 | 7 (36.84) | |||
| 0.5 | 19 (100) | |||
| 0.6 | 19 (100) | |||
| 0.7 | 19 (100) | |||
| 0.8 | 19 (100) | |||
| O128 | 7 | 0.1 | 0 (0) | <0.001 |
| 0.2 | 0 (0) | |||
| 0.3 | 0 (0) | |||
| 0.4 | 6 (85.71) | |||
| 0.5 | 7 (100) | |||
| 0.6 | 7 (100) | |||
| 0.7 | 7 (100) | |||
| 0.8 | 7 (100) |
| Species | N° Strains | Cinnamon Essential Oil (µL/mL) | Strains Inhibited (%) | p-Value |
|---|---|---|---|---|
| Laying hens | 91 | 0.1 | 0 (0) | <0.001 |
| 0.2 | 9 (9.90) | |||
| 0.3 | 59 (64.83) | |||
| 0.4 | 91 (100) | |||
| 0.5 | 91 (100) | |||
| Turkeys | 16 | 0.1 | 0 (0) | <0.001 |
| 0.2 | 1 (6.25) | |||
| 0.3 | 8 (50) | |||
| 0.4 | 16 (100) | |||
| 0.5 | 16 (100) | |||
| Broilers | 10 | 0.1 | 0 (0) | <0.001 |
| 0.2 | 1 (10) | |||
| 0.3 | 5 (50) | |||
| 0.4 | 10 (100) | |||
| 0.5 | 10 (100) | |||
| TOTAL | 117 | 0.1 | 0 (0) | <0.001 |
| 0.2 | 11 (9.4) | |||
| 0.3 | 72 (61.53) | |||
| 0.4 | 117 (100) | |||
| 0.5 | 117 (100) |
| Serogroups | N° Strains | Cinnamon Essential Oil (µL/mL) | Strains Inhibited (%) | p-Value |
|---|---|---|---|---|
| O78 | 54 | 0.1 | 0 (0) | <0.001 |
| 0.2 | 7 (12.96) | |||
| 0.3 | 47 (87.04) | |||
| 0.4 | 54 (100) | |||
| 0.5 | 54 (100) | |||
| O2 | 37 | 0.1 | 0 (0) | <0.001 |
| 0.2 | 4 (10.81) | |||
| 0.3 | 25 (67.57) | |||
| 0.4 | 37 (100) | |||
| 0.5 | 37 (100) | |||
| O139 | 19 | 0.1 | 0 (0) | <0.001 |
| 0.2 | 0 (0) | |||
| 0.3 | 0 (0) | |||
| 0.4 | 19 (100) | |||
| 0.5 | 19 (100) | |||
| O128 | 7 | 0.1 | 0 (0) | <0.001 |
| 0.2 | 0 (0) | |||
| 0.3 | 0 (0) | |||
| 0.4 | 7 (100) | |||
| 0.5 | 7 (100) |
Disclaimer/Publisher’s Note: The statements, opinions and data contained in all publications are solely those of the individual author(s) and contributor(s) and not of MDPI and/or the editor(s). MDPI and/or the editor(s) disclaim responsibility for any injury to people or property resulting from any ideas, methods, instructions or products referred to in the content. |
© 2023 by the authors. Licensee MDPI, Basel, Switzerland. This article is an open access article distributed under the terms and conditions of the Creative Commons Attribution (CC BY) license (https://creativecommons.org/licenses/by/4.0/).
Share and Cite
Casalino, G.; Dinardo, F.R.; D’Amico, F.; Bozzo, G.; Bove, A.; Camarda, A.; Lombardi, R.; Dimuccio, M.M.; Circella, E. Antimicrobial Efficacy of Cinnamon Essential Oil against Avian Pathogenic Escherichia coli from Poultry. Animals 2023, 13, 2639. https://doi.org/10.3390/ani13162639
Casalino G, Dinardo FR, D’Amico F, Bozzo G, Bove A, Camarda A, Lombardi R, Dimuccio MM, Circella E. Antimicrobial Efficacy of Cinnamon Essential Oil against Avian Pathogenic Escherichia coli from Poultry. Animals. 2023; 13(16):2639. https://doi.org/10.3390/ani13162639
Chicago/Turabian StyleCasalino, Gaia, Francesca Rita Dinardo, Francesco D’Amico, Giancarlo Bozzo, Antonella Bove, Antonio Camarda, Roberto Lombardi, Michela Maria Dimuccio, and Elena Circella. 2023. "Antimicrobial Efficacy of Cinnamon Essential Oil against Avian Pathogenic Escherichia coli from Poultry" Animals 13, no. 16: 2639. https://doi.org/10.3390/ani13162639
APA StyleCasalino, G., Dinardo, F. R., D’Amico, F., Bozzo, G., Bove, A., Camarda, A., Lombardi, R., Dimuccio, M. M., & Circella, E. (2023). Antimicrobial Efficacy of Cinnamon Essential Oil against Avian Pathogenic Escherichia coli from Poultry. Animals, 13(16), 2639. https://doi.org/10.3390/ani13162639

